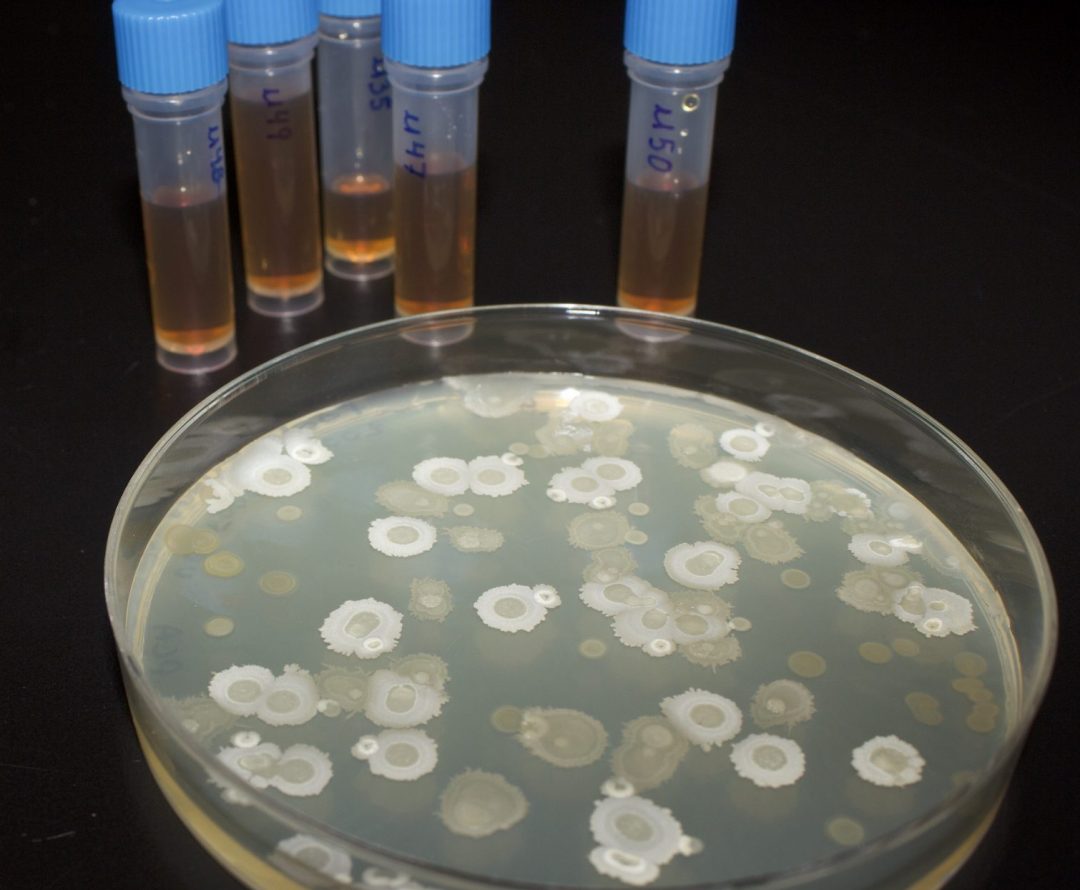
img 8093 scaled e1768505761991

Éra Clean ÉcoSol

Éra Clean ÉcoSol est une biosolution de bactéries bénéfiques qui limite le développement de phytoravageurs en sécrétant des molécules bioactives et en monopolisant l’espace et les nutriments disponibles. Grâce à leurs enzymes performantes, les bactéries de Éra Clean ÉcoSol lutte aussi contre le développement des mauvaises odeurs et la perte d’adhérence des planchers en dégradant la matière organique accumulée sur le plancher et dans les ca niveaux.
 Pour le milieu serricole
Pour le milieu serricole
Éliminer les souillures solides et liquides non adhérentes sur le plancher et les caniveaux puis humidifier. Diluer Éra Clean ÉcoSol à 1% (10ml/L) dans le réservoir du vaporisateur. Bien agiter et vaporiser. Sans rinçage.

Principaux avantages :
Limite le développement de phytoravageurs en introduisant un microbiome bénéfique.
Lutte contre les mauvaises odeurs et les phénomènes de glissement des planchers grâce à la biodégradation enzymatique de la matière organique.
Effet synergique avec Éra Clean BioSol et les autres agents de biocontrôle.
Mode d'action :
- Souches bactérienne productrice d'enzymes dégradeur de matières organiques. élimine les niches de développement potentiel de maladie.
- Nos souches bactérienne bénéfiques entre en compétition avec les possibles microorganismes pathogène de l'environnement.
- Agit à titre de première barrière biologique contre les maladies. C'est le pouvoir de notre système d'ingénierie du microbiome de la serre.
Fiche de données de sécurités
Pour une utilisation optimale et sécuritaire de notre produit Era Clean ÉcoSol, veuillez vous référer à sa fiche de données de sécurité.

Ingénierie du microbiome
Cultiver un microbien sain au sein de votre serre assure un environnement de croissance végétale optimal et réduit significativement les risques d'implantation de maladies qui peuvent occasionner des pertes financières. Notre système d'ingénierie du microbiote représente une révolution dans le domaine de l'hygiène des serres. Prenez le contrôle de vos cultures grâce à notre gamme de produits Éra Clean!


Tableau d'application
 Type de culture Type de culture |
 Taux d'application Taux d'application |
 Fréquence Fréquence |
|---|---|---|
|
Souillures solides et liquides
Plancher et les caniveaux |
|
|